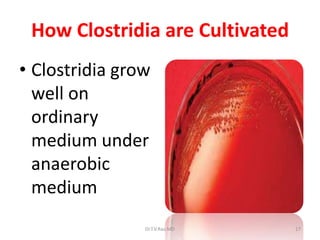
How Clostridia are Cultivated
• Clostridia grow
  well on
  ordinary
  medium under
  anaerobic
  medium
                Dr.T.V.Rao MD    17

Clostridium perfringens is a gram-positive, anaerobic bacterium that can cause gas gangrene. It forms spores that allow it to survive in soil and intestines. C. perfringens produces several toxins that damage tissues and cause diseases like gas gangrene. The bacterium thrives under low-oxygen conditions in dead or damaged tissue where it releases toxins and enzymes that destroy muscle and skin. Its toxins and enzymes damage cells and spread the infection, resulting in tissue necrosis if not treated with antibiotics.